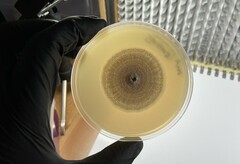
Aspergillus pragensis
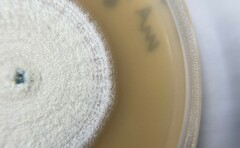
Aspergillus pragensis
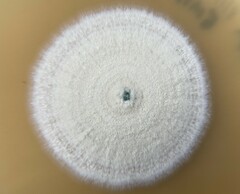
Aspergillus pragensis

Aspergillus pragensis: taxon details and analytics
- Domain
- Kingdom
- Fungi
- Phylum
- Ascomycota
- Class
- Eurotiomycetes
- Order
- Eurotiales
- Family
- Aspergillaceae
- Genus
- Aspergillus
- Species
- Aspergillus pragensis
- Scientific Name
- Aspergillus pragensis
Summary description from Wikipedia:
Aspergillus pragensis
Aspergillus pragensis is a species of fungus in the genus Aspergillus. It is from the Candidi section. The species was first described in 2014. It has been reported to produce chlorflavonin, polar compound X, terphenyllin, 3-hydroxyterphenyllin, chlorflavonin, metabolite, 6-epi-stephacidin A, and terphenyllin.
...Images from inaturalist.org observations:
We recommend you sign up for this excellent, free service.